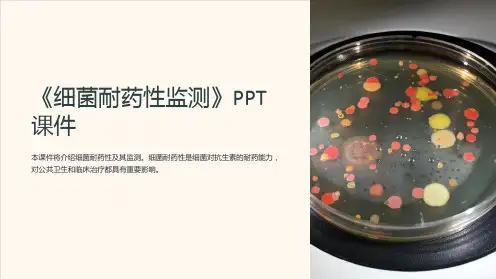

第四章 细菌耐药性检测
- 格式:ppt
- 大小:1.64 MB
- 文档页数:20

细菌耐药性监测
1.细菌耐药性监测监测临床分离细菌耐药性发生情况,包括临床上一些重要的耐药细菌的分离率,如MRSA.耐万古霉素肠球菌(VRE)和泛耐药的铜绿假单胞菌(PDR-PA),广谱β-内酰胺酶(ESBLS)的革兰阴性细菌等。
2.监测调查对象临床标本分离的病原菌。
3.监测内容细菌、抗菌药物、药物敏感结果。
4.监测方法统计、分析微生物室分离的细菌和药物敏感结果。
5.资料分析
(1)不同病原体的构成比。
(2)主要革兰阳性细菌的构成比及对抗菌药物的耐药率。
(3)主要革兰阴性细菌的构成比及对抗菌药物的耐药率。
(4)MRSA占金黄色葡萄球菌的构成比及分离绝对数,对抗菌药物的耐药率。
(5)PDR-PA的构成比及绝对分离数。
(6)VRE占肠球菌属细菌的构成比及分离绝对数,对抗菌药物的耐药率。
(7)革兰阴性细菌ESBLs的构成比及分离绝对数,对抗菌药物的耐药率。
6.总结和反馈结合以往资料总结并公布监测结果,向临床医师和医院药事管理机构反馈。

细菌耐药性检测方法传统检测方法主要包括药敏试验和漏斗法。
药敏试验通过将不同的抗生素与待检细菌进行共培养,观察细菌的生长情况,可以确定细菌对不同抗生素的敏感性。
漏斗法又称为浓度梯度法,将一系列不同浓度的抗生素加入含有细菌的琼脂平板培养基中,观察细菌生长的情况,通过最小抑菌浓度(MIC)来确定细菌的耐药性。
然而,传统的检测方法有一些不足之处,包括需要较长的检测时间、操作复杂、耗时耗力、存在人为误差等。
因此,近年来,分子检测方法逐渐应用于细菌耐药性的检测。
分子检测方法主要包括PCR技术、基因芯片技术和下一代测序技术。
PCR技术(聚合酶链式反应)是一种快速、高效、敏感的检测技术,通过扩增特定基因片段来判定细菌的耐药性。
该技术可以快速检测出是否存在耐药基因,并可通过测序等方法进一步确定具体基因型。
基因芯片技术则可以同时检测多个耐药相关基因,具有高通量、快速、精确度高的优点。
而下一代测序技术则可以对细菌的基因组进行全面分析,包括基因序列、变异信息等,对于耐药性的研究提供了更多的信息。
传统检测方法和分子检测方法在细菌耐药性检测中都具有一定的适用性,可以根据具体的实验要求和资源情况选择合适的方法。
对于临床应用而言,传统检测方法的优势在于成熟、经济、稳定,但无法提供细菌的详细基因型信息;而分子检测方法则具有高通量、高灵敏度、高特异性的优势,但需要较复杂的实验设备和操作技术。
细菌耐药性的检测方法在临床、食品安全、环境监测等领域具有重要的应用价值。
通过检测细菌的耐药性,可以指导临床合理使用抗生素,减少抗生素滥用,避免耐药细菌的产生和传播;在食品安全领域,可以掌握食品中耐药细菌的情况,保障食品的质量安全;在环境监测领域,可以及时发现环境中的耐药菌,为环境卫生管理提供参考依据。
综上所述,细菌耐药性的检测方法既有传统的药敏试验和漏斗法,也有分子检测的PCR技术、基因芯片技术和下一代测序技术。
各种方法各有优缺点,可以根据具体实验需求和资源条件选择合适的方法。


细菌耐药性检测方法1、细菌耐药表型检测:判断细菌对抗菌药物的耐药性可根据NCCLS标准,通过测量纸片扩散法、肉汤稀释法和E试验的抑菌圈直径、MIC值和IC值获得。
也可通过以下方法进行检测:(1)耐药筛选试验:以单一药物的单一浓度检测细菌的耐药性被称为耐药筛选试验,临床上常用于筛选耐甲氧西林葡萄球菌、万古霉素中介的葡萄球菌、耐万古霉素肠球菌及氨基糖苷类高水平耐药的肠球菌等。
(2)折点敏感试验:仅用特定的抗菌药物浓度(敏感、中介或耐药折点MIC),而不使用测定MIC时所用的系列对倍稀释抗生素浓度测试细菌对抗菌药物的敏感性,称为折点敏感试验。
(3)双纸片协同试验:双纸片协同试验是主要用于筛选产超广谱β-内酰胺酶(ESBLs)革兰阴性杆菌的纸片琼脂扩散试验。
若指示药敏纸片在朝向阿莫西林/克拉维酸方向有抑菌圈扩大现象(协同),说明测试菌产生超广谱β-内酰胺酶(4)药敏试验的仪器化和自动化:全自动细菌鉴定及药敏分析仪如:Vitek-2、BD-Pheonix、Microscan等运用折点敏感试验的原理可半定量测定抗菌药物的MIC值。
2.β-内酰胺酶检测:主要有碘淀粉测定法(iodometric test)和头孢硝噻吩纸片法(nitrocefin test)。
临床常用头孢硝噻吩纸片法,β-内酰胺酶试验可快速检测流感嗜血杆菌、淋病奈瑟菌、卡他莫拉菌和肠球菌对青霉素的耐药性。
如β-内酰胺酶阳性,表示上述细菌对青霉素、氨苄西林、阿莫西林耐药;表示葡萄球菌和肠球菌对青霉素(包括氨基、羧基和脲基青霉素)耐药。
3.耐药基因检测:临床可检测的耐药基因主要有:葡萄球菌与甲氧西林耐药有关的MecA 基因,大肠埃希菌与β-内酰胺类耐药有关的blaTEM、blaSHV、blaOXA基因,肠球菌与万古霉素耐药有关的vanA、vanB、vanC、vanD基因。
检测抗菌药物耐药基因的方法主要有:PCR扩增、PCR-RFLP分析、PCR-SSCP 分析、PCR-线性探针分析、生物芯片技术、自动DNA 测序4.特殊耐药菌检测(1)耐甲氧西林葡萄球菌检测:对 1цg苯唑西林纸片的抑菌圈直径≤10㎜,或其MIC≥4цg/ml的金黄色葡萄球菌和对1цg苯唑西林纸片的抑菌圈直径≤17㎜,或MIC≥0.5цg/ml 的凝固酶阴性葡萄球菌被称为耐甲氧西林葡萄球菌(MRS)。

细菌耐药性监测和防控管理制度第一章总则第一条目的和依据1.为了保障医院医疗质量,有效监测和防控细菌耐药性的传播和扩散,订立本规章制度。
2.本制度依据《中华人民共和国传染病防治法》《中华人民共和国医疗机构条例》等相关法律法规。
第二条适用范围1.本制度适用于医院内全部科室、各级医务人员、护理人员等相关人员。
2.各科室依据本制度的要求,订立符合本科室特点的相关管理方法和操作规程。
第三条定义1.细菌耐药性:指细菌对抗生素或其他药物产生的抗药物性。
2.监测:指对细菌耐药性进行系统、长期的监测和评估。
3.防控:指对细菌耐药性的传播和扩散采取各种措施,包含防备、监测、隔离、教育、培训等。
第二章细菌耐药性监测和评估第四条细菌耐药性监测和评估的目的1.确定医院细菌耐药性的流行情况和趋势。
2.发现和监测细菌的变异和新显现的耐药性。
3.评估细菌耐药性对患者治疗和医院感染掌控的影响。
第五条细菌耐药性监测和评估的内容1.对呼吸系统、消化系统、泌尿系统、血液系统、皮肤和软组织等科室常见感染细菌的耐药性进行监测。
2.对每一批次进货的抗生素进行抽样检测。
3.对医院内患者的细菌耐药性进行监测,并将监测结果报送给医疗质量管理部门和临床科室。
第六条细菌耐药性监测和评估的方法1.手记标本:依据不同感染部位和病情,选择合适的标本进行手记。
2.分别培养:对手记的标本进行细菌分别和培养,并进行鉴定。
3.药敏试验:对培养的细菌进行药敏试验,确定其对不同抗生素的敏感性和耐药性。
4.数据统计和分析:对检测结果进行统计和分析,形成监测报告。
第三章细菌耐药性防控第七条医院细菌耐药性防控的原则1.提高医务人员的感染掌控和手卫生意识。
2.合理使用抗生素,避开滥用和过度使用。
3.定期培训和教育医务人员,提高细菌耐药性防控知识和技能。
第八条感染防备与掌控1.严格执行无菌操作规范,避开交叉感染。
2.加强医疗废物管理,确保废物的正确处理,防止感染扩散。
第九条手卫生1.医务人员在接触患者前后必需进行手卫生。

细菌耐药监测制度第一章总则第一条为了提高细菌耐药性监测的科学性、有效性和规范性,保障患者的医疗安全和公共卫生,订立本规章制度。
第二条本制度适用于本医院全部临床科室、医技科室以及临床研究单位。
第三条细菌耐药性监测是指对不同类型的细菌在不同人群中的耐药性情况进行监测分析的工作。
第四条细菌耐药性监测的目的是及时掌握细菌耐药性的变动趋势,为合理使用抗生素、订立感染掌控措施和改进治疗供应科学依据。
第二章细菌耐药性监测的对象第五条细菌耐药性监测的对象包含但不限于以下几类细菌:1.革兰阳性菌:如金黄色葡萄球菌、肠球菌、链球菌等;2.革兰阴性菌:如大肠杆菌、产气荚膜梭菌、克雷伯菌等;3.难以培养的非典型菌:如结核分枝杆菌、麻风杆菌等。
第三章细菌耐药性监测的内容与方法第六条细菌耐药性监测的内容包含以下几方面:1.细菌的种类和数量;2.细菌对不同抗生素的耐药性;3.细菌耐药性的变动趋势;4.细菌耐药性相关的流行病学特征。
第七条细菌耐药性监测的方法包含以下几种:1.手记标本:依据不同疾病和临床需要,手记相应的标本,如血液、尿液、呼吸道分泌物等;2.细菌培养与分别:将标本作无菌处理后,进行培养分别,得到纯种细菌菌株;3.抗生素敏感试验:对不同细菌菌株进行抗生素敏感试验,获得耐药性数据;4.统计分析与报告:对细菌耐药性数据进行统计分析,编制监测报告,及时通报相关科室和管理部门。
第四章细菌耐药性监测的管理第八条细菌耐药性监测的责任主体为医院感染掌控科。
第九条医院感染掌控科的职责包含但不限于以下几方面:1.负责组织和实施细菌耐药性监测工作;2.统筹协调各临床科室和医技科室的合作,确保监测工作的顺利进行;3.订立和修订细菌耐药性监测工作流程和操作规范,保证工作的质量和规范;4.对监测结果进行分析和解读,供应科学依据和建议,引导临床用药和感染掌控工作;5.定期向医院领导和相关部门报告监测结果,及时通报紧要的细菌耐药性情况。
第十条各临床科室和医技科室的职责包含但不限于以下几方面:1.搭配医院感染掌控科的工作,按要求进行标本手记和数据录入;2.及时向医院感染掌控科报告细菌耐药性相关信息,如感染病例、抗生素使用情况等;3.搭配医院感染掌控科的要求,参加细菌耐药性监测结果的分析和讨论,并接受相关建议。




细菌耐药性检测方法1、细菌耐药表型检测:判断细菌对抗菌药物的耐药性可根据NCCLS标准,通过测量纸片扩散法、肉汤稀释法和E试验的抑菌圈直径、MIC值和IC值获得。
也可通过以下方法进行检测:(1)耐药筛选试验:以单一药物的单一浓度检测细菌的耐药性被称为耐药筛选试验,临床上常用于筛选耐甲氧西林葡萄球菌、万古霉素中介的葡萄球菌、耐万古霉素肠球菌及氨基糖苷类高水平耐药的肠球菌等。
(2)折点敏感试验:仅用特定的抗菌药物浓度(敏感、中介或耐药折点MIC),而不使用测定MIC时所用的系列对倍稀释抗生素浓度测试细菌对抗菌药物的敏感性,称为折点敏感试验。
(3)双纸片协同试验:双纸片协同试验是主要用于筛选产超广谱β-内酰胺酶(ESBLs)革兰阴性杆菌的纸片琼脂扩散试验。
若指示药敏纸片在朝向阿莫西林/克拉维酸方向有抑菌圈扩大现象(协同),说明测试菌产生超广谱β-内酰胺酶(4)药敏试验的仪器化和自动化:全自动细菌鉴定及药敏分析仪如:Vitek-2、BD-Pheonix、Microscan等运用折点敏感试验的原理可半定量测定抗菌药物的MIC值。
2.β-内酰胺酶检测:主要有碘淀粉测定法(iodometric test)和头孢硝噻吩纸片法(nitrocefin test)。
临床常用头孢硝噻吩纸片法,β-内酰胺酶试验可快速检测流感嗜血杆菌、淋病奈瑟菌、卡他莫拉菌和肠球菌对青霉素的耐药性。
如β-内酰胺酶阳性,表示上述细菌对青霉素、氨苄西林、阿莫西林耐药;表示葡萄球菌和肠球菌对青霉素(包括氨基、羧基和脲基青霉素)耐药。
3.耐药基因检测:临床可检测的耐药基因主要有:葡萄球菌与甲氧西林耐药有关的MecA 基因,大肠埃希菌与β-内酰胺类耐药有关的blaTEM、blaSHV、blaOXA基因,肠球菌与万古霉素耐药有关的vanA、vanB、vanC、vanD基因。
检测抗菌药物耐药基因的方法主要有:PCR扩增、PCR-RFLP分析、PCR-SSCP 分析、PCR-线性探针分析、生物芯片技术、自动DNA测序4.特殊耐药菌检测(1)耐甲氧西林葡萄球菌检测:对1цg苯唑西林纸片的抑菌圈直径≤10㎜,或其MIC≥4цg/ml的金黄色葡萄球菌和对1цg苯唑西林纸片的抑菌圈直径≤17㎜,或MIC≥0.5цg/ml 的凝固酶阴性葡萄球菌被称为耐甲氧西林葡萄球菌(MRS)。
细菌耐药性检测方法1、细菌耐药表型检测:判断细菌对抗菌药物的耐药性可根据NCCLS标准,通过测量纸片扩散法、肉汤稀释法和E试验的抑菌圈直径、MIC值和IC值获得。
也可通过以下方法进行检测:(1)耐药筛选试验:以单一药物的单一浓度检测细菌的耐药性被称为耐药筛选试验,临床上常用于筛选耐甲氧西林葡萄球菌、万古霉素中介的葡萄球菌、耐万古霉素肠球菌及氨基糖苷类高水平耐药的肠球菌等。
(2)折点敏感试验:仅用特定的抗菌药物浓度(敏感、中介或耐药折点MIC),而不使用测定MIC时所用的系列对倍稀释抗生素浓度测试细菌对抗菌药物的敏感性,称为折点敏感试验。
(3)双纸片协同试验:双纸片协同试验是主要用于筛选产超广谱β-内酰胺酶(ESBLs)革兰阴性杆菌的纸片琼脂扩散试验。
若指示药敏纸片在朝向阿莫西林/克拉维酸方向有抑菌圈扩大现象(协同),说明测试菌产生超广谱β-内酰胺酶(4)药敏试验的仪器化和自动化:全自动细菌鉴定及药敏分析仪如:Vitek-2、BD-Pheonix、Microscan等运用折点敏感试验的原理可半定量测定抗菌药物的MIC值。
2.β-内酰胺酶检测:主要有碘淀粉测定法(iodometric test)和头孢硝噻吩纸片法(nitrocefin test)。
临床常用头孢硝噻吩纸片法,β-内酰胺酶试验可快速检测流感嗜血杆菌、淋病奈瑟菌、卡他莫拉菌和肠球菌对青霉素的耐药性。
如β-内酰胺酶阳性,表示上述细菌对青霉素、氨苄西林、阿莫西林耐药;表示葡萄球菌和肠球菌对青霉素(包括氨基、羧基和脲基青霉素)耐药。
3.耐药基因检测:临床可检测的耐药基因主要有:葡萄球菌与甲氧西林耐药有关的MecA基因,大肠埃希菌与β-内酰胺类耐药有关的blaTEM、blaSHV、blaOXA基因,肠球菌与万古霉素耐药有关的vanA、vanB、vanC、vanD基因。
检测抗菌药物耐药基因的方法主要有:PCR扩增、PCR-RFLP分析、PCR-SSCP 分析、PCR-线性探针分析、生物芯片技术、自动DNA测序4.特殊耐药菌检测(1)耐甲氧西林葡萄球菌检测:对1цg苯唑西林纸片的抑菌圈直径≤10㎜,或其MIC≥4цg/ml的金黄色葡萄球菌和对1цg苯唑西林纸片的抑菌圈直径≤17㎜,或MIC≥0.5цg/ml的凝固酶阴性葡萄球菌被称为耐甲氧西林葡萄球菌(MRS)。
细菌耐药性检测要领之阳早格格创做1、细菌耐药表型检测:推断细菌对于抗菌药物的耐药性可根据NCCLS尺度,通过丈量纸片扩集法、肉汤密释法战E 考查的抑菌圈直径、MIC值战IC值赢得.也可通过以下要领举止检测:(1)耐药筛选考查:以简单药物的简单浓度检测细菌的耐药性被称为耐药筛选考查,临床上时常使用于筛选耐甲氧西林葡萄球菌、万古霉素中介的葡萄球菌、耐万古霉素肠球菌及氨基糖苷类下火仄耐药的肠球菌等.(2)合面敏感考查:仅用特定的抗菌药物浓度(敏感、中介或者耐药合面MIC),而没有使用测定MIC时所用的系列对于倍密释抗死素浓度尝试细菌对于抗菌药物的敏感性,称为合面敏感考查.(3)单纸片协共考查:单纸片协共考查是主要用于筛选产超广谱β-内酰胺酶(ESBLs)革兰阳性杆菌的纸片琼脂扩集考查.若指示药敏纸片正在往背阿莫西林/克推维酸目标有抑菌圈夸大局面(协共),证明尝试菌爆收超广谱β-内酰胺酶(4)药敏考查的仪器化战自动化:齐自动细菌审定及药敏分解仪如:Vitek-2、BD-Pheonix、Microscan等使用合面敏感考查的本理可半定量测定抗菌药物的MIC值.2.β-内酰胺酶检测:主要有碘淀粉测定法(iodometrictest)战头孢硝噻吩纸片法(nitrocefin test).临床时常使用头孢硝噻吩纸片法,β-内酰胺酶考查可赶快检测流感嗜血杆菌、淋病奈瑟菌、卡他莫推菌战肠球菌对于青霉素的耐药性.如β-内酰胺酶阳性,表示上述细菌对于青霉素、氨苄西林、阿莫西林耐药;表示葡萄球菌战肠球菌对于青霉素(包罗氨基、羧基战脲基青霉素)耐药.3.耐药基果检测:临床可检测的耐药基果主要有:葡萄球菌取甲氧西林耐药有闭的MecA基果,大肠埃希菌取β-内酰胺类耐药有闭的blaTEM、blaSHV、blaOXA基果,肠球菌取万古霉素耐药有闭的vanA、vanB、vanC、vanD基果.检测抗菌药物耐药基果的要领主要有:PCR扩删、PCR-RFLP分解、PCR-SSCP 分解、PCR-线性探针分解、死物芯片技能、自动DNA测序4.特殊耐药菌检测(1)耐甲氧西林葡萄球菌检测:对于 1цg苯唑西林纸片的抑菌圈直径≤10㎜,或者其MIC≥4цg/ml的金黄色葡萄球菌战对于1цg苯唑西林纸片的抑菌圈直径≤17㎜,或者MIC≥цg/ml的凝固酶阳性葡萄球菌被称为耐甲氧西林葡萄球菌(MRS).对于MRS没有管其体中药敏考查截止,所有的β-内酰胺类药物战β-内酰胺/β-内酰胺酶压造剂均隐现临床无效;绝大普遍的MRS常为多沉耐药,耐药范畴包罗氨基糖甙类、大环内酯类、四环素类等.(2)耐青霉素肺炎链球菌检测:当对于1ццg/ml均应视为耐青霉素肺炎链球菌(PRSP).临床治疗隐现PRSP对于氨卞西林、氨卞西林/舒巴坦、头胞克肟、头胞唑肟,临床治疗疗效很好,但是应检测对于头胞直紧、头胞噻肟战好洛培北等的MIC以推断是可对于那些抗死素敏感.(3)耐万古霉素肠球菌检测:肠球菌对于30цg万古霉素纸片抑菌圈直径≤14㎜或者MIC≥32цg/ml被称为耐万古霉素肠球菌(VRE).针对于多沉万古霉素药物暂时尚无灵验治疗要领,但是对于青霉素敏感的VRE可用青霉素战庆大霉素共同治疗,若对于青霉素耐药而没有是下火仄耐氨基糖甙类可用壁霉素+庆大霉素.(4)产超广谱β-内酰胺酶的肠杆菌科细菌检测:超广谱β-内酰胺酶是一种能火解青霉素、广谱头孢菌素及单胺类的酶,主要由克雷伯菌、肠杆菌等细菌爆收.当通过筛选法时对于头孢泊肟、头孢他啶(10цg/片)抑菌圈≤22㎜或者氨直北、头孢噻肟(30цg/片)≤27㎜的菌株经头孢他啶(30цg/片)、头孢他啶/克推维酸(30/10цg);头孢噻肟(30цg/片)、头孢噻肟/克推维酸(30/10цg)二组表型确证考查,其截止为二组中所有一组药物加克推维酸取没有加克推维酸的抑菌圈相比,删大值≥5㎜时推断为产ESBL菌株(图7-13).产ESBL克雷伯菌战大肠埃希菌没有管其体中药物敏感考查截止怎么样,对于青霉素、头孢菌素战氨直北治疗无效.。